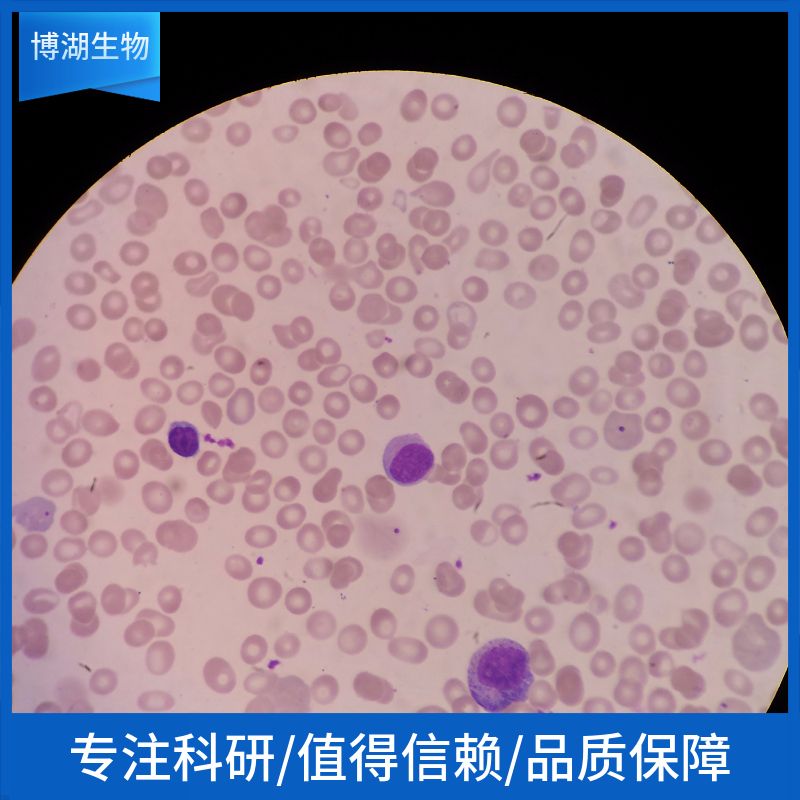
产品封面图

万千商家帮你免费找货
0 人在求购买到急需产品
- 详细信息
- 文献和实验
- 技术资料
- 细胞类型:
原代细胞
- 肿瘤类型:
详见说明书
- 供应商:
上海博湖
- 库存:
48
- 生长状态:
贴壁培养
- 运输方式:
包邮
- 是否是肿瘤细胞:
否
- 细胞形态:
呈鹅卵石样,不规则细胞
- 免疫类型:
详见说明书
- 物种来源:
详见说明书
- 组织来源:
实验动物的正常眼组织
- 规格:
5×105
商品属性:
| 产品名称 | 规格 | 型号 |
| 大鼠脉络膜微血管内皮细胞 | 5×105 | P-X1730 |
细胞详述
脉络膜新生血管(choroidal neovascularization,CNV)已成为眼科学领域的研究热点之一,目前多数体外研究应用的是人脐静脉内皮细胞或主动脉内皮细胞等容易得到的大血管内皮细胞。由于血管内皮细胞具有器官特异性和组织特异性,用大血管内皮细胞的研究结果很难客观、准确地解释CNV的发生机制。因此,建立脉络膜微血管内皮细胞(choroidal microvascular endothelial cells,CEC)体外培养体系,对深入研究CNV相关疾病具有十分重要的价值。
细胞特性
1)组织来源于实验动物的正常眼组织。
2)细胞鉴定:CD31免疫荧光染色为阳性。
3)经鉴定细胞纯度高于90%。
4)不含有 HIV-1、 HBV、HCV、支原体、细菌、酵母和真菌。
5)细胞生长方式:呈鹅卵石样,不规则细胞,贴壁培养。
产品的运输和保存
视天气状况和运输距离远近,公司与客户协商后选择下述方式中的一种进行。
1)1mL冻存细胞悬液装于1.8ml的冻存管中,置于装满干冰的泡沫保温盒中进行运输;收到细胞后请尽快解冻复苏细胞进行培养,如无法立刻进行复苏操作,冻存细胞可在-80℃的条件下保存1个月。
2)T-25培养瓶充满完全培养基后进行常温运输;收到细胞后请镜下观察细胞生长状态,如铺瓶率超过85%请立即进行传代操作,如悬浮的细胞较多,请将培养瓶至于培养箱中静置过夜以帮助未死亡的悬浮细胞能够再次贴壁。
产品使用
1)本产品仅能用于科研
2)本产品
未通过直接用于活体动物和人的审核
3)本产品未通过用于活体诊断的审核



Hs 746T(人胃癌细胞) 5×106cells/瓶×2单1酸阿糖腺苷;阿糖腺苷单1酸ARA-AMP;Vidarabine monophosphate质量规格:>98%,BR
Gibco 17100017 Collagenase Type I 1gα-萘黄酮α-Naphthoflavone质量规格:>98%, 进口
人晶状体上皮细胞裂解物HLEpiCL紫脲酸铵Murexide质量规格:ACS
ALDH3A1 Others Human 人 ALDH3A1 杆状病毒-昆虫细胞裂解液 (阳性对照) 盐酸羟胺Hydroxylammonium chloride质量规格:AR
小鼠色素瘤细胞;B163,3'-二甲基联萘胺3,3'-Dimethylnaphthidine质量规格:>97%,进分
正常大鼠肾细胞;NRK桑色素(标准品)质量规格:HPLC≥98%,标准品Morin
ACVR1 Others Cynomolgus 食蟹猴 ALK-2 / ACVR1 / ALK2 人细胞裂解液 (阳性对照) 沙苑子苷A(标准品)质量规格:HPLC≥98%,标准品Complanatoside A
肝动脉内皮细胞Many types of cells包装:5 × 105方(1ml)山栀苷甲酯(标准品)质量规格:HPLC≥98%,标准品Shanzhiside methylester
Hurt-78细胞,人T细胞瘤 小鼠胚胎成纤维细胞,3T3-swiss albino细胞 人肺泡上皮细胞cDNAHPAEpiC cDNA商陆皂苷甲(标准品)质量规格:HPLC≥98%,标准品Esculentoside A
P3/NSI/1-Ag4-1 [NS-1] (小鼠骨髓瘤细胞) 5×106cells/瓶×2三乙酰基-β-环糊精(>97.0%(HPLC))质量规格:>97.0%(HPLC)Triacetyl-β-cyclodextrin
大鼠肝窦内皮细胞完全培养基 100mL钼酸钠500克
293T/17人胚肾细胞 Human embryonic kidney cell line 293T/17 DMEM+10%FBS2,2-二氧基炳烷 2,2-DiMqthoxypropcnq;
FGF19 Protein Human 重组人 FGF19 蛋白2-1克RT
BEL-7405(人肝癌细胞) 5×106cells/瓶×2 人真皮成纤维母细胞-新生HDF-n溴紫葡萄糖肉汤25克
人内皮细胞cDNAHLEC cDNA517-23-72-乙酰丁内酯2-Acetylbutyrolactone
大鼠脉络膜微血管内皮细胞PrimaCell™小鼠子宫成纤维细胞试剂盒
PrimaCell™小鼠卵巢颗粒细胞试剂盒
PrimaCell™小鼠卵巢成纤维细胞试剂盒
PrimaCell™小鼠子宫内膜上皮细胞试剂盒
PrimaCell™小鼠淋巴成纤维细胞试剂盒
风险提示:丁香通仅作为第三方平台,为商家信息发布提供平台空间。用户咨询产品时请注意保护个人信息及财产安全,合理判断,谨慎选购商品,商家和用户对交易行为负责。对于医疗器械类产品,请先查证核实企业经营资质和医疗器械产品注册证情况。
文献和实验体外培养模型已被广泛应用于血脑屏障的研究、脑血管疾病的病理生理及分子生物学研究、新药筛选、脑微血管内皮细胞生理生化及药理学研究等领域。而大多数体内实验采用大鼠为动物模型,而且大鼠具有较多的细胞生物学研究所需的抗体可用,因此进行大鼠脑微血管内皮细胞的培养具有重要的意义。自从Panula等[2]首次成功培养大鼠脑微血管内皮细胞以来,国内外有关大鼠脑微血管内皮细胞的分离和培养方法已有较多的报道,我们发现国内的方法多以组织匀浆、两次尼龙网过滤分离脑微血管段为主[3,4],也有采用酶消化、梯度离心及尼龙网过滤
【摘 要】目的:培养脑皮质微血管内皮细胞。方法:取1~5d Wistar乳鼠脑皮质,经不同孔径的筛网过滤后,用胶原酶振荡消化获得的微血管内皮细胞进行培养,用Ⅷ因子相关抗原免疫组化鉴定。结果:培养的细胞呈单层贴壁生长,7~9d呈典型的铺路卵石样征象。结论:建立了一种简便易行的培养脑皮质微血管内皮细胞的方法。【关键词】 细胞培养;微血管内皮细胞;Wistar大鼠脑微血管内皮细胞是构成血脑屏障的主要成分,具有特殊的形态结构和机能,在许多病理状态下起重要作用[1]。建立脑微血管内皮细胞体外培养,可获
。 选用80克SD大鼠(雌雄不限,购自复旦大学实验动物部),1%戊巴比妥钠(1ml/100g)腹腔注射麻醉,75%酒精浸泡5min消毒,将大鼠移至超净台进行操作,止血钳固定四肢,逐层打开胸腔,暴露心脏,剪开心包,由升主动脉处剪下心脏,放入D-Hanks平衡盐缓冲液中.冲净心腔中的血液,辨清心脏解剖结构,去除大血管、左右心房以及右心室和室间隔,保留左心室,小心去除心内膜及心外膜,用眼科剪剪碎余下的心室肌约2mm见方,滴加1ml进口胎牛血清.均匀接种于处理过的50ml培养瓶中,放入37℃、5%CO2
技术资料暂无技术资料 索取技术资料